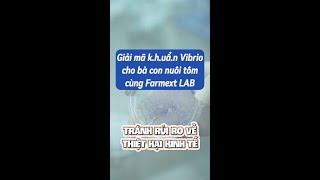

Farmext LAB có mặt tại Cần giờ??? Phòng LAB xét nghiệm thủy sản hiện đại nhất Việt Nam!!! #tôm #cá
Tác giả: Phạm Mét Tơ | Đóng góp bởi: Phạm Mét Tơ
02-07-2024 | 0773688669 | 1334 | Báo hỏng
Theo dõi kênh
Farmext LAB có mặt tại Cần giờ??? Phòng LAB xét nghiệm thủy sản hiện đại nhất Việt Nam!!! #tôm #cá
Bình luận